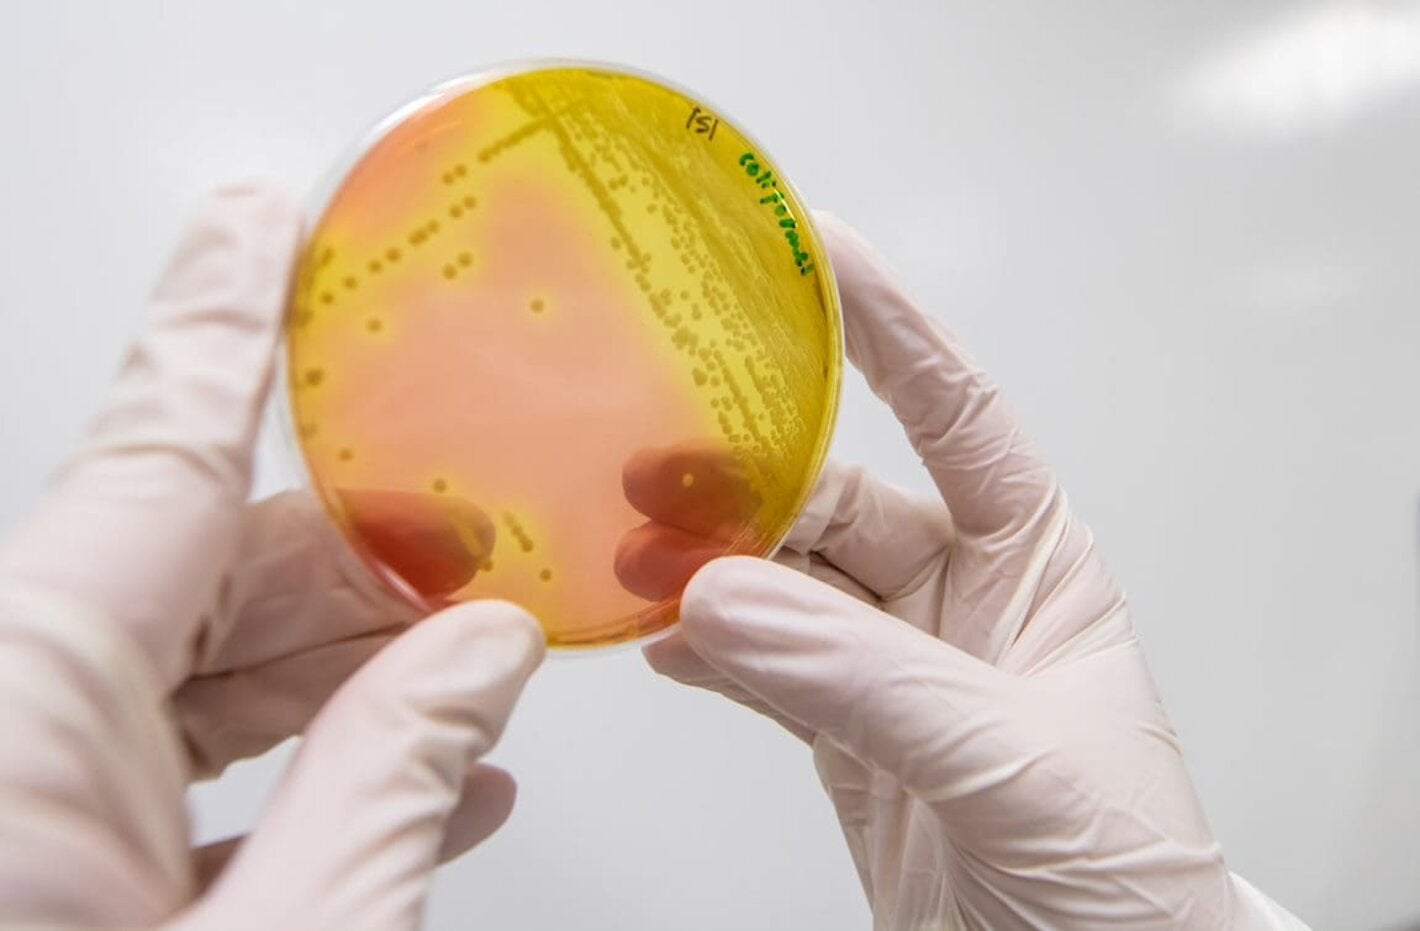

18 May 2024
Con el objetivo de abordar los desafíos cambiantes frente a la resistencia a los antimicrobianos (RAM), la Organización Mundial de la Salud (OMS) ha actualizado la Lista de Patógenos Bacterianos Prioritarios (BPPL, por sus siglas en inglés).
En su versión 2024 incluye 24 patógenos, que abarcan 15 familias resistentes a los antibióticos, las cuales se clasifican en tres categorías: crítica, alta y media.
“Para elaborar la lista de patógenos bacterianos prioritarios se ha determinado la carga mundial de infecciones por bacterias farmacorresistentes y se ha analizado su repercusión en la salud pública. Por ello, esta lista es fundamental para orientar la inversión y superar los obstáculos que dificultan la obtención de nuevos antibióticos y el acceso a ellos”, indicó la doctora Yukiko Nakatani, subdirectora general interina de la OMS para la Resistencia a los Antimicrobianos.
En relación con la lista presentada en 2017 se han producido algunos cambios y no solo se llama la atención sobre ellos, sino que se invita a realizar intervenciones específicas para contener los microorganismos resistentes y multirresistentes, teniendo en cuenta cada realidad particular. De igual forma, se han incorporado nuevas pruebas e información científica relevante que sea útil para los grupos de investigación sobre RAM y para los encargados del desarrollo de nuevos antibióticos.
Básicamente se eliminaron cinco combinaciones de patógenos y antibióticos y se añadieron cuatro combinaciones nuevas, y se decidió que los Enterobacterales resistentes a las cefalosporinas de tercera generación figuren en un grupo independiente dentro de la categoría de prioridad crítica, lo que pone de manifiesto su carga de morbimortalidad.
La infección por Pseudomonas aeruginosa resistente a los carbapenémicos deja la categoría crítica y pasa a la de prioridad alta, teniendo en cuenta que, según recientes estudios, hay una reducción de su resistencia a nivel global, lo que refleja el impacto positivo de los programas y estrategias para su contención, aunque no se puede bajar la guardia.
Entre los patógenos de prioridad media figuran los estreptococos de los grupos A y B (que aparecen por primera vez en esta BPPL 2024), Streptococcus pneumoniae y Haemophilus influenzae, que registran una elevada carga de morbilidad y, por ende, requieren mayor vigilancia, sobre todo en las poblaciones más vulnerables, de las que hacen parte los niños y los ancianos, en especial en los lugares con menos recursos económicos.
Al presentar la BPPL 2024, la OMS enfatiza en la necesidad de adoptar un enfoque integral de la salud pública para hacer frente a la resistencia a los antimicrobianos, teniendo en cuenta cuatro pilares fundamentales: prevención de las infecciones, acceso a los servicios de salud esenciales, diagnóstico oportuno y preciso, y tratamiento adecuado y de calidad garantizada.
La lista de patógenos bacterianos prioritarios de la OMS correspondiente a 2024 incluye estas bacterias:
Prioridad crítica:
- Acinetobacter baumannii resistente a los carbapenémicos.
- Enterobacterales resistentes a las cefalosporinas de tercera generación.
- Enterobacterales resistentes a los carbapenémicos.
- Mycobacterium tuberculosis resistente a la rifampicina (se ha incluido luego de un análisis independiente con criterios adaptados paralelamente y tras la posterior aplicación de una matriz adaptada de análisis para decidir en función de varios criterios).
Prioridad alta:
- Salmonella Typhi resistente a las fluoroquinolonas.
- Shigella spp. resistente a las fluoroquinolonas.
- Enterococcus faecium resistente a la vancomicina.
- Pseudomonas aeruginosa resistente a los carbapenémicos.
- Salmonelas no tifoideas resistentes a las fluoroquinolonas.
- Neisseria gonorrhoeae resistente a las cefalosporinas de tercera generación y/o a las fluoroquinolonas.
- Staphylococcus aureus resistente a la meticilina.
Prioridad media:
- Estreptococos del grupo A resistentes a los macrólidos.
- Streptococcus pneumoniae resistente a los macrólidos.
- Haemophilus influenzae resistente a la ampicilina.
- Estreptococos del grupo B resistentes a los macrólidos.



